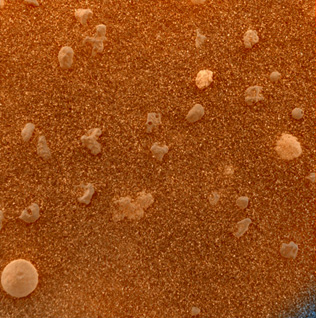
skyeye

Magnified Mars
At first glance, this sharp, color close-up gives the strong impression of pebbles
strewn over a sandy beach. But the picture is one of the first microscopic images of
another planet, captured by the Opportunity rover on its tenth sol on the martian
surface at Meridiani Planum. The patch of soil measures about 3 centimeters (1.2 inches)
across. It is shown in shades approximating what the eye might see, obtained by combining
pictures of the soil with and without the microscopic imager's orange-tinted dust cover in
place. Searching for evidence of past water on Mars, researchers note that both volcanic
and water-related accretion processes could have produced the striking circular grain at the
lower left. However, other investigations now indicate the soil near the lander contains olivine,
an iron-bearing mineral common in volcanic rocks, while a signature of the iron mineral hematite
was found in soil around a nearby rocky outcrop. On planet Earth, hematite often forms in
association with liquid water.